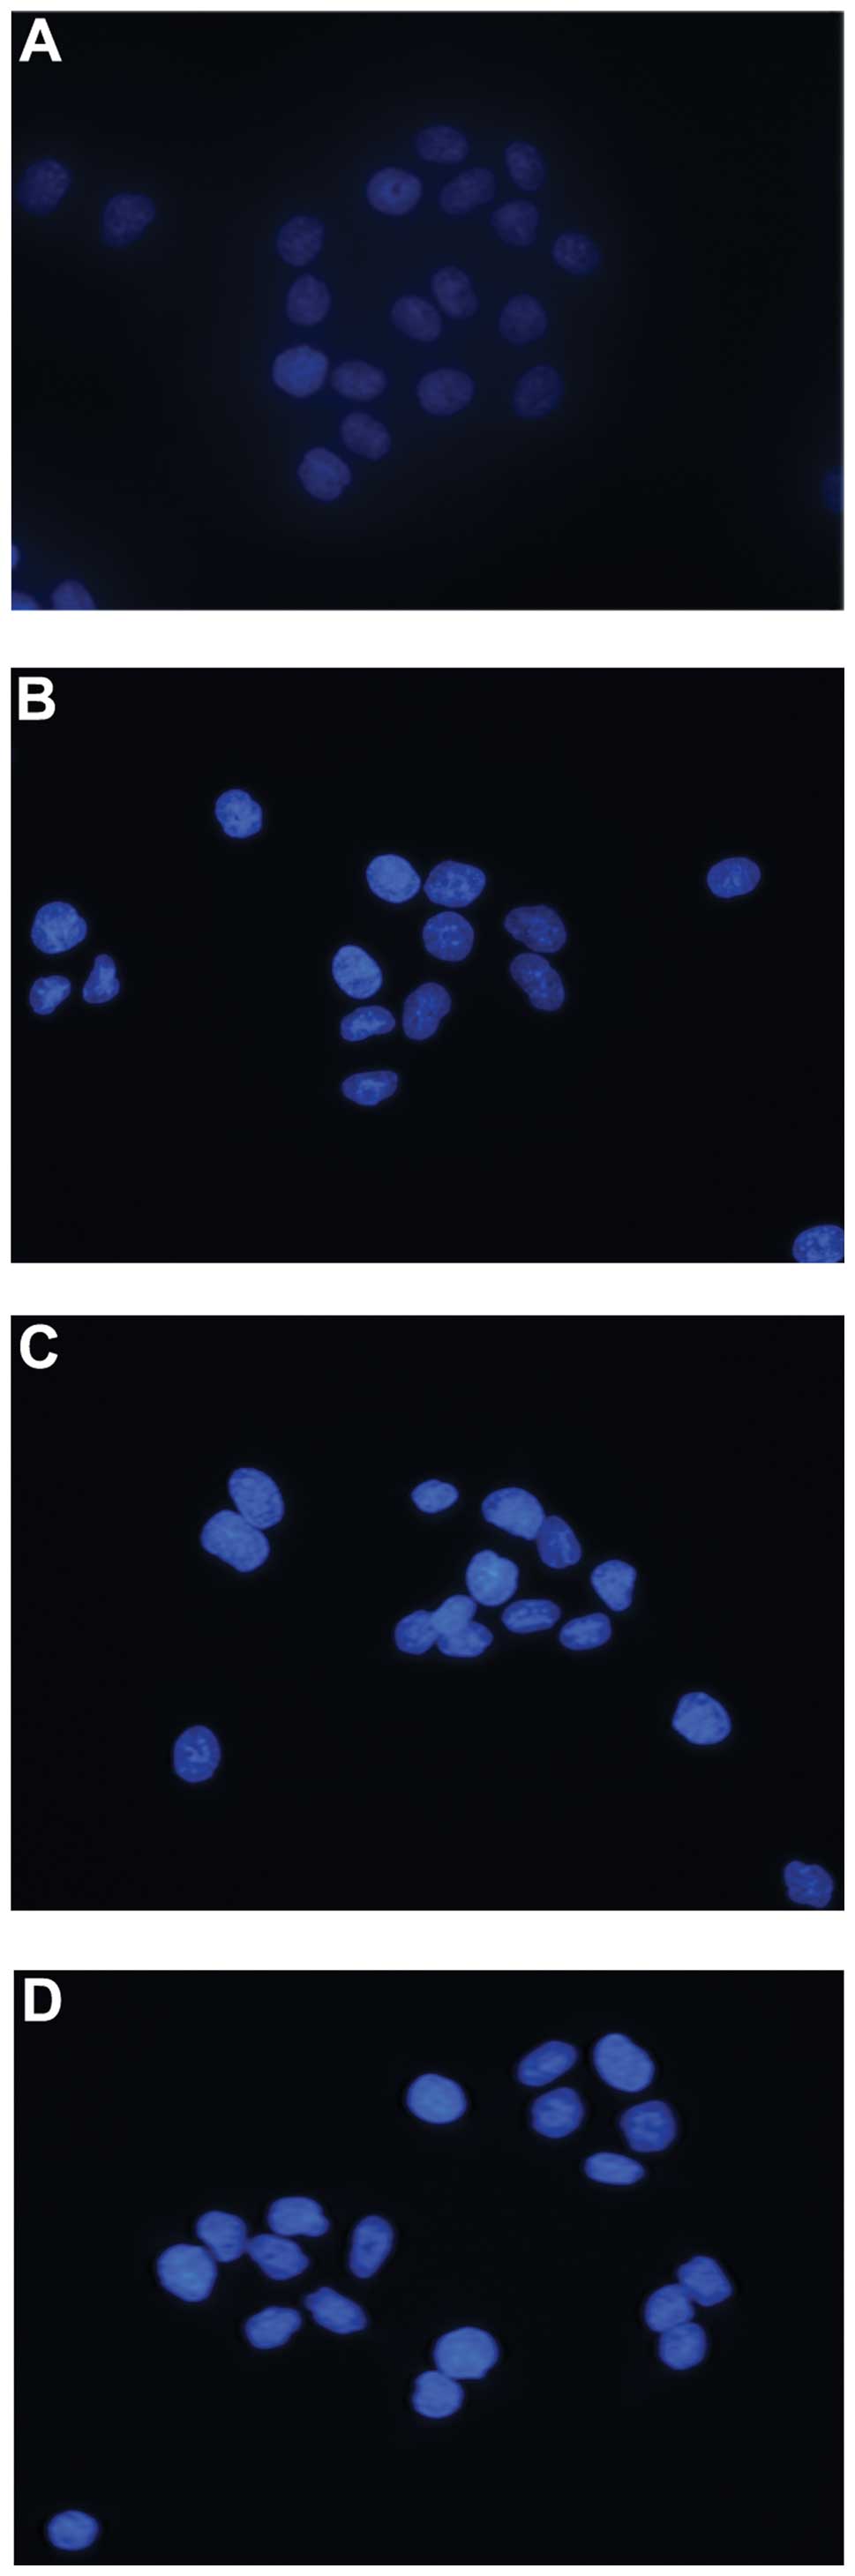

Introduction
Esophageal cancer is a common malignant
gastrointestinal disease, and the global incidence and mortality
has been increasing in recent years (1,2).
China has a high incidence of esophageal cancer, with esophageal
squamous cell carcinoma being the predominant histological subtype
(3). When patients are diagnosed,
the majority have already developed late-stage cancer and thus are
not eligible for surgical treatment; therefore, chemotherapy is the
main treatment option for advanced esophageal cancer.
5-fluorouracil (5-FU) has been employed as a
first-line chemotherapeutic agent in esophageal cancer for a number
of years, and has been demonstrated to successfully promote the
efficiency rate and the patient’s quality of life (4). However, this treatment may result in
side effects, including bone marrow suppression, local irritation
and gastrointestinal disorders, including nausea, vomiting and
appetite loss. Therefore, identifying anticancer drugs with high
efficiency and low toxicity, and which may be able to be used in
combination therapy, is of increasing importance.
Puerarin, a well-known isoflavone-C-glycoside, has
been identified as a major constituent of Pueraria lobata.
Puerarin has been used in Traditional Chinese Medicine for
millennia, and has been shown to possess various beneficial effects
for patients with Parkinson’s disease (5), diabetes (6), hypertension (7), osteoporosis (8,9),
alcoholism (10) and
cardiovascular and cerebrovascular diseases (11–13).
Furthermore, numerous studies have demonstrated the anticancer
activity of puerarin in animal models as well as in a variety of
cancer cell lines (14–19). However, the antitumor effect of
puerarin on esophageal cancer have been rarely reported (16). The present study thus examined the
activity of puerarin combined with 5-FU against esophageal cancer
in vitro and in vivo.
Materials and methods
Chemicals and cell culture
Puerarin was obtained from Sigma-Aldrich (P5555;
Sigma-Aldrich Co. LLC, Shanghai, China). The puerarin stock
solution was prepared at 100 mM in serum-free culture medium and
stored at −20°C. 5-FU (F6627; Sigma-Aldrich), was dissolved in
Dulbecco’s modified Eagle’s medium (DMEM; Gibco-BRL, Gaithersburg,
MD, USA) to yield a 20 mM stock solution, which was stored at
−20°C. The Eca-109 esophageal cancer cell line was obtained from
the China Center for Type Culture Collection (Wuhan, China). The
cells were cultured in DMEM supplemented with 10% fetal bovine
serum (FBS) and 1% antibiotics (100 μg/ml streptomycin and 100 IU
penicillin; Genom, Hangzhou, China) in a humidified incubator at
37°C under 5% CO2.
Cell viability inhibition
The inhibitive effects of puerarin and 5-FU on the
in vitro growth of Eca-109 cells were determined using the
cell counting kit-8 (CCK-8; Dojindo Molecular Technologies, Inc.,
Kunamoto, Japan). The cells (5×103 cells per well) were
seeded in 96-well microtitre plates. Following exposure to puerarin
(400, 800, 1,600, 3,200, 6,400 μM), 5-FU (40, 80, 160, 320, 640 μM)
or puerarin + 5-FU for 48 h, 10 μl CCK-8 solution [5 mg/ml in
phosphate-buffered saline (PBS)] was added to each well and the
plates were incubated for an additional 2 h at 37°C. The CCK-8
solution in the medium was removed and the optical density at 450
nm was determined by an iMark Microplate Absorbance Reader
(Bio-Rad, Hercules, CA, USA). Each assay was performed in
triplicate. The results are expressed as the inhibition rate (IR):
IR = (A×B)/A×100%, where A and B are the absorbance of the control
and sample groups, respectively, after 48 h of incubation.
Hoechst 33258 assay for apoptosis
Apoptotic cells were detected by Hoechst 33258
staining following the manufacturer’s instructions (C0003; Beyotime
Institute of Biotechnology, Shanghai, China). The cells were
cultured in DMEM for 12 h following seeding in a sterile six-well
plate, and then fixed in 0.5 ml methanol for 30 min and washed with
PBS twice. 0.5 ml Hoechst 33258 reagent was used to stain the
apoptotic cells in the dark at room temperature for 5 min following
exposure to puerarin (160 μM), 5-FU (160 μM) alone or puerarin and
5-FU combined for 48 h. The cells were then rinsed with PBS twice.
Apoptotic cells were identified on the basis of morphological
changes in the nuclear assembly by observing chromatin condensation
and fragment staining using Hoechst 33258. The stained cells were
examined and photographed under a fluorescence microscope (Olympus
1X71; Olympus Corporation, Tokyo, Japan) at an excitation
wavelength of 330–380 nm. In each group, ten microscopic fields
were selected randomly and the cells were counted.
Annexin V/propidium iodide (PI)
staining
To quantify the percentage of cells undergoing
apoptosis, the Annexin V-fluorescein isothiocyanate (FITC) kit
(Multi-Sciences Biotechnology Co., Ltd., Hangzhou, China) was used
according to the manufacturer’s instructions. Briefly, cells were
incubated for either 24 h or 48 h with puerarin and 5-FU alone or
in combination. The cells were then washed twice with cold PBS and
resuspended in fluorescein isothiocyanate conjugated annexin V
binding buffer at a concentration of 1×106 cells/ml.
Following incubation, 100 μl solution was transferred to a 5-ml
culture tube, and 5 μl Annexin V-FITC and 10 μl PI were added. The
tube was gently centrifuged at 1,000 × g and incubated for 15 min
at room temperature in the dark. At the end of the incubation, 400
μl binding buffer was added and the cells were analyzed immediately
by flow cytometry (FACSAria™; Beckman Coulter, Inc., Fullerton, CA,
USA). Flow cytometric analysis was performed using
CellQuest™ software (BD Biosciences, Franklin Lakes, NJ,
USA).
Xenograft tumor model
All procedures were performed in compliance with the
National Institutes of Health Guide for the Care and Use of
Laboratory Animals, and the study was approved by the Ethics
Committee for Animal Research of Wuhan University, China. Male
BALB/c nude mice, aged 5–6 weeks, were purchased from the Center
for Animal Experiments of Wuhan University (Wuhan, China). The mice
weighed 16–18 g at the beginning of the experiment. The mice were
maintained in autoclaved filter-top micro-isolator cages with
autoclaved water and sterile food provided ad libitum. The
cages were maintained in an isolator unit provided with filtered
air. Tumor cells used for inoculation were grown in culture and
harvested as described above. A total of 24 mice were inoculated
subcutaneously with injections of 1×107 cells/mouse; a
further six mice inoculated with saline acted as a control group.
Tumor sizes were determined using micrometer calipers and mice with
similarly sized tumors were randomly divided into four groups (with
six mice/group): Saline control group; puerarin 25 mg/kg/day group;
5-FU 12 mg/kg/day group; and puerarin + 5-FU combination group.
Following 3 weeks, all mice were sacrificed by spinal dislocation
and the xenograft tumors were removed and measured. Tumor volume
(TV) was calculated using the following formula: TV
(mm3) = d2xD/2, where d and D signify the
shortest and the longest diameters, respectively.
TUNEL assay
For histological examination, the tumor tissues were
fixed in 10% buffered formalin and embedded in paraffin, and 4 μm
tissue sections were prepared. The TUNEL assay was performed with
an in situ apoptosis detection kit (Roche, Branchburg, NJ,
USA) according to the manufacturer’s instructions. Positive cells
were identified, counted (six random fields per slide) and analyzed
by an Olympus-BX53 upright fluorescence microscope (Olympus).
Evaluation of side effects
The livers and kidneys of the mice from the
different groups were fixed in 10% buffered formalin, and the
preserved tissues were cleaned in running water, processed for
histological examination according to the conventional methods and
stained with haematoxylin and eosin. The morphology of any lesions
observed was classified and registered by a skilled histologist who
was blinded to the treatment groups. Blood was collected by cardiac
puncture using heparin-rinsed 1-ml syringes (20 gauge needles). The
levels of alanine aminotransferase (ALT), aspartate
aminotransferase (AST), blood urea nitrogen (BUN) and serum
creatinine (Cr), biomarkers of liver and renal injury were detected
by a Beckman 700 spectrophotometer (Beckman-Coulter, Chicago, IL,
USA).
Statistical analysis
Data were subjected to non-parametric analysis using
the Mann-Whitney rank sum test. P<0.05 was considered to
indicate a statistically significant difference. Statistical
analyses were performed using SPSS 17.0 software (SPSS, Inc.,
Chicago, IL, USA).
Results
Effects of drug exposure on the growth of
the Eca-109 esophageal cancer cell line
The inhibition of proliferation by puerarin and 5-FU
in the Eca-109 cells was assessed after 48 h of drug exposure,
following 24 h culture in drug-free medium. As shown in Fig. 1, after 48 h of treatment, growth of
the Eca-109 cells was significantly inhibited in a dose-dependent
manner (P<0.01). The mean [± standard deviation (SD)] inhibition
rate was 6.56±0.04% at 400 μM puerarin and 90.76±0.83% at 6,400 μM.
5-FU at 40 μM exhibited an inhibition rate of 7.10±0.06%, while the
rate at 640 μM was 76.56±4.71%. In addition, the effect of puerarin
and 5-FU combined was higher than that of puerarin or 5-FU alone
and the difference was identified to be statistically significant
(P<0.05). This indicated that puerarin and 5-FU exhibited a
synergistic effect on inhibiting the proliferation of Eca-109
cells.
Apoptosis induced by puerarin and
5-FU
Apoptosis induced by puerarin and 5-FU was confirmed
using Annexin V/PI staining to detect externalization of
phosphatidylserine on the cell membrane. As shown in Fig. 2, the proportion of Annexin
V-positive/PI-negative cells increased progressively in Eca-109
cells incubated at low concentrations of puerarin (400 μM) and/or
5-FU (40 μM) for 48 h. Puerarin and 5-FU alone significantly
promoted apoptosis compared with the control group (P<0.05),
although the combined effects of the two drugs were greater than
the effects of puerarin or 5-FU alone (P<0.05).
Hoechst 33258 staining was used to detect the
morphological features of apoptotic cells induced by puerarin and
5-FU in vitro, which revealed that apoptotic bodies
containing nuclear fragments were generated in apoptotic cells. The
mean (±SD) of apoptotic cells in the control, puerarin, 5-FU and
combined group were 3.67±2.16, 51.67±8.45, 55.17±10.17 and
83.0±9.21, respectively. Therefore, the percentages of apoptotic
cells induced by either puerarin and 5-FU alone or the two drugs
combined were significantly elevated compared with that in the
control group (P<0.05, Fig. 3).
Furthermore, the apoptotic rate in the combined treatment group was
significantly greater than that of either respective treatment
alone (P<0.05, Fig. 3).
Antitumor effects in vivo
Following the investigation of apoptosis in Eca-109
cells in vitro, the antitumor effect of puerarin and 5-FU
was evaluated in xenograft tumor mouse models. None of the mice
died over the course of treatment and all 24 mice successfully
developed tumor xenografts. On day 14, the tumor xenografts reached
a mean size of 216.53±32.29 mm3. The 24 mice were
randomly divided into four groups as described above. No
statistically significant differences were detected among the sizes
of the tumors in the different groups. Subsequently, the mice were
administered the different treatments. The results revealed that
puerarin and 5-FU administered either in combination or
individually exhibited significant inhibitory effects in
vivo, with tumor volumes and weights in the mice in these
groups all significantly reduced as compared with the saline
control group (P<0.05, Table
I), and the average tumor volume in the combination group was
significantly lower than that in either the puerarin or the 5-FU
group (P<0.05, Table I). The
mean (±SD) tumor volume in the control group was 1,015.26±108.88
mm3 at the end of the experiment, and the tumor
inhibition rate of puerarin combined with 5-FU was 89.06%, whereas
the inhibition rates of puerarin and 5-FU alone were 76.93 and
72.21%, respectively (Table I).
The mean tumor weights in the different groups are shown in
Table I; the inhibition rates were
87.48, 65.93 and 61.81%, for the combined treatment, puerarin only
and 5-FU only groups, respectively. These results demonstrated that
the antitumor effect of puerarin combined with 5-FU was superior to
the effects of the drugs when used individually.
 | Table IInhibitory effects of puerarin and
5-FU on Eca-109 xenograft tumors in nude mice. |
Table I
Inhibitory effects of puerarin and
5-FU on Eca-109 xenograft tumors in nude mice.
| Group | No. | Volume
(mm3) | Inhibition rate
(%) | Weight (g) | Inhibition rate
(%) |
|---|
| Puerarin | 6 | 234.23±15.17ab | 76.93 | 0.358±0.161ab | 65.93 |
| 5-FU | 6 | 282.10±58.87ab | 72.21 | 0.402±0.151ab | 61.81 |
| Puerarin + 5-FU | 6 | 111.09±34.79b | 89.06 | 0.132±0.067b | 87.48 |
| Control | 6 | 1,015.26±108.88 | | 1.052±0.522 | |
Tumor tissues isolated from the xenograft mice of
the four groups were assessed using the TUNEL assay; representative
micrographs are shown in Fig. 4.
The tumors derived from combination-treated mice exhibited a
markedly higher count of apoptotic bodies compared with the control
tumors, suggesting that puerarin potentiates the activity of 5-FU,
which includes the suppression of cellular viability and increased
apoptosis of tumor cells in vivo.
Evaluation of side effects
At the end of the experiment, the nude mice were
necropsied. No clear metastasis, peptic ulcer and haemorrhage, or
injury to the liver and kidney was visible to the naked eye.
Hepatic toxicity was monitored by quantitative
analysis of the ALT and AST expression levels that served as
biochemical markers of liver injury (20). The hepatic toxicity induced by
different treatments is shown in Table II. ALT and AST activities in the
serum were not significantly elevated compared with the control
group (P>0.05), and no differences between the combination,
puerarin and 5-FU groups compared with the control groups were
identified (P>0.05). No observable gross or histological changes
were observed in the livers of either the treated groups or the
control groups; similar results were obtained for renal injury.
 | Table IIEffect of puerarin combined with 5-FU
or alone on hepatic and renal function. |
Table II
Effect of puerarin combined with 5-FU
or alone on hepatic and renal function.
| Group | No. | ALT (U/l) | AST (U/l) | BUN (μmol/l) | Cr (μmol/l) |
|---|
| Puerarin | 6 | 35.33±5.75 | 131.17±22.16 | 7.38±1.22 | 16.54±3.86 |
| 5-FU | 6 | 37.67±8.24 | 134.33±24.08 | 7.39±0.88 | 16.63±2.52 |
| Puerarin + 5-FU | 6 | 37.17±12.51 | 152.33±20.47 | 7.84±1.10 | 18.74±4.87 |
| Tumor control | 6 | 32.83±12.07 | 129.83±21.32 | 7.22±0.53 | 15.81±2.91 |
| Normal control | 6 | 33.33±7.55 | 124.50±22.49 | 7.09±1.26 | 16.81±8.65 |
Discussion
Esophageal cancer is the seventh most frequent cause
of cancer-related mortality worldwide (2). Although the level of diagnosis and
treatment has greatly improved, the mortality rate remains high,
and the median overall five-year survival rate has not improved in
the last 40 years. The rate of complete resection by surgical
treatment is low; therefore, chemotherapy is the predominant
treatment method. 5-FU is one of the most commonly used agents in
esophageal cancer treatment, but the gradual emergence of drug
resistance and adverse effects limit its clinical application.
Puerarin has been demonstrated to exhibit antitumor
effects in various cancers, including colorectal cancer, breast
cancer and human endometrial carcinoma. Yu et al (14) reported that puerarin altered the
expression levels of apoptosis-associated genes [an increase in
B-cell lymphoma-2 associated X protein (bax) and reductions in
c-myc and B-cell lymphoma-2 (bcl-2)] and may act as a
chemopreventive and/or chemotherapeutic agent in colon cancer
cells. Wang et al (15)
evaluated the anticancer activity of puerarin nanosuspensions in
the HT-29 human colon cancer cell line in vitro and in
vivo. The results also suggested that the puerarin
nanosuspensions may serve as a chemotherapeutic agent for colon
cancer. Lin et al (17)
suggested that puerarin may act as a chemopreventive and/or
chemotherapeutic agent against breast cancer as it inhibited cell
proliferation via upregulation of p21/Waf1, p53, caspase-9 and bax.
In addition, Yu et al (19)
reported that puerarin may be a natural alternative to estrogen
replacement therapy for endometrial cancers and the potential
mechanism may be associated with the downregulation of the
transcription factors activator protein-1 or c-jun. However, there
are few studies addressing the effects of puerarin on esophageal
cancer (16).
In the present study, the administration of either
puerarin or 5-FU alone was found to significantly inhibit the
proliferation of esophageal cancer cells in a dose-dependent
manner. However, the combined effect of puerarin and 5-FU on
esophageal cancer in vitro or in vivo was superior to
that of either puerarin or 5-FU alone, and the combined effect was
synergistic. In addition, puerarin combined with 5-FU induced
apoptosis to a greater extent than that of puerarin or 5-FU alone.
The results are notable and encourage further studies into the
mechanism of this synergistic effect.
Apoptosis is a tightly regulated cellular process.
Two predominant signaling pathways in cell apoptosis have been
described: The mitochondria-independent death receptor signaling
pathway and the mitochondrial signaling pathway (21,22).
5-FU inhibits the thymic pyrimidine nucleotidase of tumor cells and
affects DNA stability (23). A
number of experiments have observed that 5-FU also induces
apoptosis of gastroenteral carcinoma cells, which proceeded through
p53, bcl-2, caspase-3 and caspase-8 (24–28).
In the present study, puerarin combined with 5-FU at lower
concentrations was identified to promote apoptosis; however, the
mechanism for this remains elusive.
The present study found no evident side effects of
the drug treatments (ulcer and haemorrhage, or injury of the liver
and kidney) during the entire course of the experiment. Compared
with the control group, no significant differences in the
expression levels of ALT, AST, BUN and Cr were detected in the
treatment groups (P>0.05). Therefore, puerarin combined with
5-FU may not increase the toxicity of chemotherapy.
In conclusion, puerarin combined with 5-FU was
demonstrated to exhibit a significantly greater antitumor effect
than either puerarin or 5-FU used alone. Furthermore, the toxicity
did not increase when the drugs were used in combination, which
indicated that there may be potential for the combined use of these
drugs in the clinical treatment of esophageal cancer.
Acknowledgements
The authors would like to thank Mr. Hong Xia from
the Key Laboratory of Hubei Province for Digestive System Disease
for assistance in data collection.
References
|
1
|
Jemal A, Bray F, Center MM, et al: Global
cancer statistics. CA Cancer J Clin. 61:69–90. 2011. View Article : Google Scholar
|
|
2
|
Enzinger PC and Mayer RJ: Esophageal
cancer. N Engl J Med. 349:2241–2252. 2003. View Article : Google Scholar : PubMed/NCBI
|
|
3
|
Tran GD, Sun XD, Abnet CC, et al:
Prospective study of risk factors for esophageal and gastric
cancers in the Linxian general population trial cohort in China.
Int J Cancer. 113:456–463. 2005. View Article : Google Scholar
|
|
4
|
Allum WH, Stenning SP, Bancewicz J, et al:
Long-term results of a randomized trial of surgery with or without
preoperative chemotherapy in esophageal cancer. J Clin Oncol.
27:5062–5067. 2009. View Article : Google Scholar : PubMed/NCBI
|
|
5
|
Song JX, Sze SC, Ng TB, et al:
Anti-Parkinsonian drug discovery from herbal medicines: what have
we got from neurotoxic models? J Ethnopharmacol. 139:698–711. 2012.
View Article : Google Scholar : PubMed/NCBI
|
|
6
|
Xie W and Du L: Diabetes is an
inflammatory disease: evidence from traditional Chinese medicines.
Diabetes Obes Metab. 13:289–301. 2011. View Article : Google Scholar : PubMed/NCBI
|
|
7
|
Zhang NB, Huang ZG, Cui WD and Ding BP:
Effects of puerarin on expression of cardiac Smad3 and Smad7 mRNA
in spontaneously hypertensive rat. J Ethnopharmacol. 138:737–740.
2011. View Article : Google Scholar : PubMed/NCBI
|
|
8
|
Mori M, Aizawa T, Tokoro M, et al: Soy
isoflavone tablets reduce osteoporosis risk factors and obesity in
middle-aged Japanese women. Clin Exp Pharmacol Physiol. 31(Suppl
2): S39–S41. 2004. View Article : Google Scholar : PubMed/NCBI
|
|
9
|
Michihara S, Tanaka T, Uzawa Y, et al:
Puerarin exerted anti-osteoporotic action independent of estrogen
receptor-mediated pathway. J Nutr Sci Vitaminol. 58:202–209. 2012.
View Article : Google Scholar : PubMed/NCBI
|
|
10
|
Benlhabib E, Baker JI, Keyler DE and Singh
AK: Effects of purified puerarin on voluntary alcohol intake and
alcohol withdrawal symptoms in P rats receiving free access to
water and alcohol. J Med Food. 7:180–186. 2004. View Article : Google Scholar
|
|
11
|
Hertog MG, Feskens EJ, Hollman PC, Katan
MB and Kromhout D: Dietary antioxidant flavonoids and risk of
coronary heart disease: the Zutphen Elderly Study. Lancet.
342:1007–1011. 1993. View Article : Google Scholar : PubMed/NCBI
|
|
12
|
Wong KH, Li GQ, Li KM, et al: Kudzu root:
traditional uses and potential medicinal benefits in diabetes and
cardiovascular diseases. J Ethnopharmacol. 134:584–607. 2011.
View Article : Google Scholar : PubMed/NCBI
|
|
13
|
Tao HQ, Meng Q, Li MH, et al: HP-β-CD-PLGA
nanoparticles improve the penetration and bioavailability of
puerarin and enhance the therapeutic effects on brain
ischemia-reperfusion injury in rats. Naunyn Schmiedebergs Arch
Pharmacol. 386:61–70. 2013.
|
|
14
|
Yu Z and Li W: Induction of apoptosis by
puerarin in colon cancer HT-29 cells. Cancer Lett. 238:53–60. 2006.
View Article : Google Scholar : PubMed/NCBI
|
|
15
|
Wang Y, Ma Y, Zheng Y, et al: In vitro and
in vivo anticancer activity of a novel puerarin nanosuspension
against colon cancer, with high efficacy and low toxicity. Int J
Pharm. 441:728–735. 2013. View Article : Google Scholar : PubMed/NCBI
|
|
16
|
Li XR, Zhang QQ, Cui YH, et al: The growth
influence on human esophageal cancer cells EC9706 induced by
puerarin. Journal of Oncology Medicine. 2010.1922–1924. 2010.(In
Chinese).
|
|
17
|
Lin YJ, Hou YC, Lin CH, et al: Puerariae
radix isoflavones and their metabolites inhibit growth and induce
apoptosis in breast cancer cells. Biochem Biophys Res Commun.
378:683–688. 2009. View Article : Google Scholar : PubMed/NCBI
|
|
18
|
Hien TT, Kim HG, Han EH, et al: Molecular
mechanism of suppression of MDR1 by puerarin from Pueraria lobata
via NF-kappaB pathway and cAMP-responsive element transcriptional
activity-dependent up-regulation of AMP-activated protein kinase in
breast cancer MCF-7/adr cells. Mol Nutr Food Res. 54:918–928. 2010.
View Article : Google Scholar
|
|
19
|
Yu C, Li Y, Chen H, et al: Decreased
expression of aromatase in the Ishikawa and RL95-2 cells by the
isoflavone, puerarin, is associated with inhibition of c-jun
expression and AP-1 activity. Food Chem Toxicol. 46:3671–3676.
2008. View Article : Google Scholar : PubMed/NCBI
|
|
20
|
Awad ME, Abdel-Rahman MS and Hassan SA:
Acrylamide toxicity in isolated rat hepatocytes. Toxicol in Vitro.
12:699–704. 1998. View Article : Google Scholar : PubMed/NCBI
|
|
21
|
Chen M and Wang J: Initiator caspases in
apoptosis signaling pathways. Apoptosis. 7:313–319. 2002.
View Article : Google Scholar
|
|
22
|
Green DR: Apoptotic pathways: ten minutes
to dead. Cell. 121:671–674. 2005. View Article : Google Scholar : PubMed/NCBI
|
|
23
|
Yeh KH, Yeh SH, Hsu CH, et al: Prolonged
and enhanced suppression of thymidylate synthase by weekly 24-h
infusion of high-dose 5-fluorouracil. Br J Cancer. 83:1510–1515.
2000. View Article : Google Scholar : PubMed/NCBI
|
|
24
|
Wu XX, Kakehi Y, Mizutani Y, et al:
Activation of caspase-3 in renal cell carcinoma cells by
anthracyclines or 5-fluorouracil. Int J Oncol. 19:19–24.
2001.PubMed/NCBI
|
|
25
|
Ikebukuro K, Adachi Y, Toki J, et al:
Morphological change, loss of deltapsi(m) and activation of
caspases upon apoptosis of colorectal adenocarcinoma induced by
5-FU. Cancer Lett. 153:101–108. 2000. View Article : Google Scholar : PubMed/NCBI
|
|
26
|
Shears LL, Ribeiro U, Kane J, et al:
apoptosis in esophageal cancer following induction
chemoradiotherapy. J Surg Res. 79:20–24. 1998. View Article : Google Scholar : PubMed/NCBI
|
|
27
|
Matsuhashi N, Saio M, Matsuo A, et al: The
evaluation of gastric cancer sensitivity to 5-FU/CDDP in terms of
induction of apoptosis: time-and p53 expression-dependency of
anti-cancer drugs. Oncol Rep. 14:609–615. 2005.PubMed/NCBI
|
|
28
|
Tian F, Fan T, Zhang Y, et al: Curcumin
potentiates the antitumor effects of 5-FU in treatment of
esophageal squamous carcinoma cells through downregulating the
activation of NF-κB signaling pathway in vitro and in vivo. Acta
Biochim Biophys Sin (Shanghai). 44:847–855. 2012.PubMed/NCBI
|